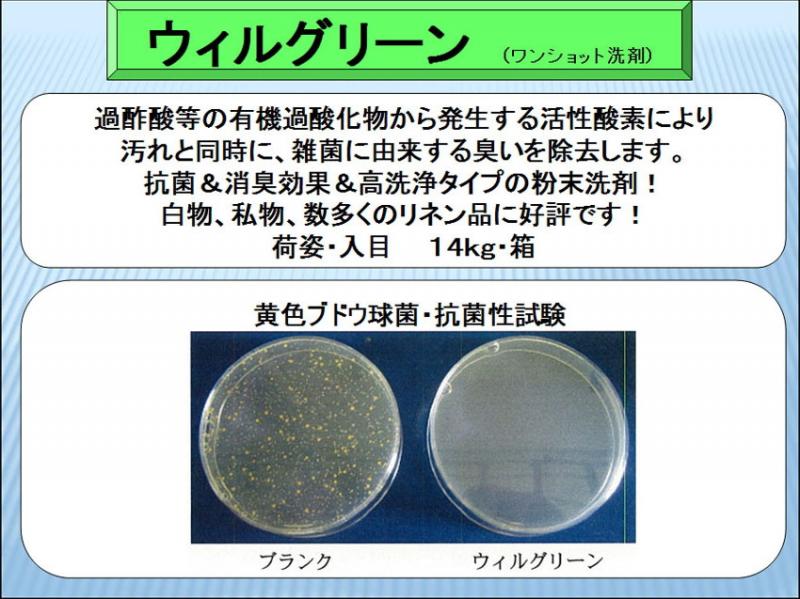

1
/
の
2
プロが使う完璧な抗菌・消臭洗剤「ウイルグリーン+」14kg
プロが使う完璧な抗菌・消臭洗剤「ウイルグリーン+」14kg
通常価格
13,700 円
通常価格
14,000 円
セール価格
13,700 円
単価
/
あたり
(税抜)配送料はチェックアウト時に計算されます。
受取状況を読み込めませんでした
共有
関連商品カテゴリ:
季節のアイテム
水洗用粉末洗剤
洗濯洗剤
洗濯洗剤その他
【製品リニューアルのお知らせ】
ウイルグリーンは近抗菌性や洗浄性・仕上がり質感性能を大幅に向上させた「ウイルグリーン+」に切り替わりました。
| 商品名 | ウイルグリーン+ |
| 荷姿 | 14kgケース |
| 効能 |
クリーニングのプロがお使いの 抗菌・消臭効果のあるワンショット洗剤 |
| 使用方法 |
【22~25kgワッシャーの場合】 本洗浄:ウイルグリーン350ml(中水位) 温度:40~60℃ 時間:15~20分 すすぎ1回目:40℃ 3分(高水位) すすぎ2回目:常温 3分(高水位) 仕上げ:洗濯物に応じて柔軟剤またはペースト剤を投入 5分(低水位) 本脱水:5分 |
■衛生洗浄■
過酢酸等の有機過酸化物から発生する活性酸素の効果により抗菌効果を発揮します。
■消臭効果■
洗浄時の抗菌効果と洗浄力で雑菌に由来する臭いも除去する事ができます。
■高い洗浄力■
厳選された洗浄成分の相乗効果により、40~60℃の洗浄温度で優れた洗浄性を発揮し、汚れ落ち・白冴えが改善されます。また袖・襟汚れもきれいに落ちますので前処理します。こちらも不要です。
■環境問題■
無リン、{PRTR法」非該当商品です。またケイ酸塩を含んでいませんので、水リサイクルシステム(RO膜)にも対応できます。